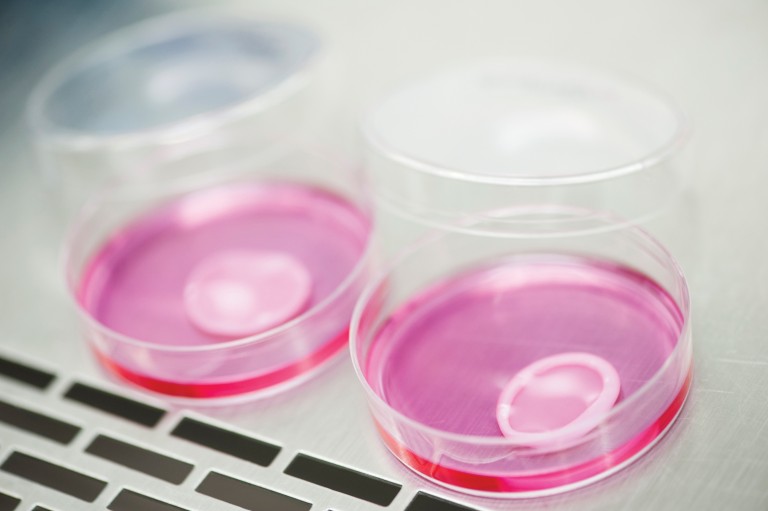
Preparação de amostra de pele desenvolvida pela professora Silvya Maria-Engler, da USP
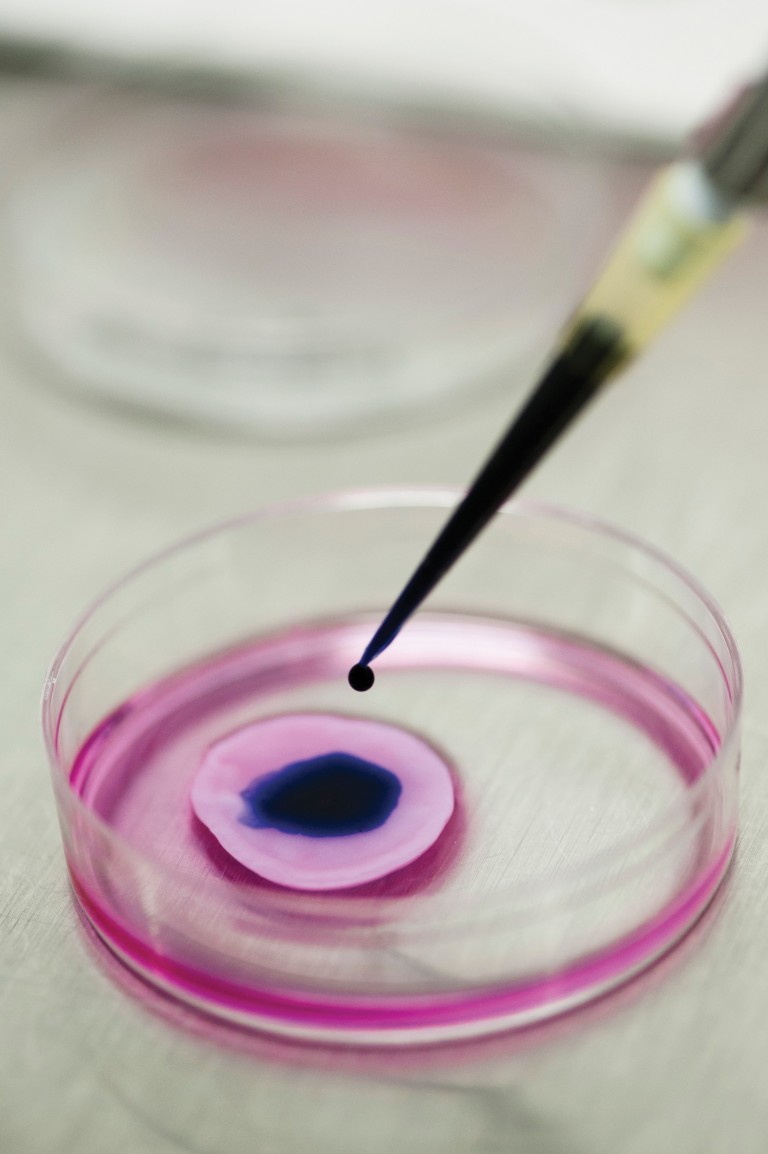
Teste de cosmético líquido sobre pele artificial na USP. Cada fragmento só pode ser usado uma vez

Pele artificial
© LÉO RAMOS
A três anos de entrar em vigor uma resolução do Conselho Nacional de Controle de Experimentação Animal (Concea) que obriga fabricantes de cosméticos e laboratórios farmacêuticos a adotarem métodos alternativos ao uso de animais em pesquisa, o Brasil fez avanços significativos no desenvolvimento de pele reconstruída em laboratório. Esse material biológico é chamado também de pele artificial, 3D ou equivalente, e tem morfologia e fisiologia similares ao tecido humano. Poderá ser usado em testes de avaliação de novos cosméticos e produtos de higiene pessoal em substituição a animais, no estudo de doenças, como melanoma e câncer de colo uterino, e no tratamento de úlceras dermatológicas crônicas e queimaduras. Empresas, institutos de pesquisa e universidades do país correm contra o tempo para desenvolver modelos nacionais de pele humana in vitro.
A pele artificial é reconstruída a partir de células humanas e demora de 10 a 30 dias para ser desenvolvida (ver infográfico). O tecido dura por volta de sete a 10 dias, período em que está pronto para ser usado. No caso dos testes de cosméticos, a nova substância deve ser aplicada sobre a pele. Em creme ou pó, o material é espalhado com auxílio de uma espátula ou uma haste flexível; se for um líquido, é pingado sobre o tecido. Depois de algumas horas, a pele in vitro é lavada para remoção da substância. No dia seguinte, os pesquisadores fazem em laboratório a contagem da quantidade de células vivas e mortas a fim de verificar o potencial corrosivo irritante do novo produto. Cada fragmento de pele reconstruída, com 1,5 centímetro (cm) a 3 cm de diâmetro, só pode ser usado uma vez.
© LÉO RAMOS

Preparação de amostra de pele desenvolvida pela
professora Silvya Maria-Engler, da USP
professora Silvya Maria-Engler, da USP
Atualmente, o mercado de pele artificial é liderado pela multinacional francesa L’Oréal, uma das gigantes do setor de cosméticos. A empresa é proprietária dos modelos Episkin e Skinethic, distribuídos em países da Europa em kits formados por 24 unidades de tecidos de pele artificial humana reconstruídos em laboratório. Além da pele completa, formada pela epiderme (camada externa) e a derme (camada logo abaixo da epiderme), a L’Oréal comercializa no exterior outros seis modelos de tecidos, entre eles uma epiderme humana reconstruída, uma epiderme pigmentada, mimetizando diferentes cores de pele, e vários tipos de epitélio, como os que compõem as mucosas da boca, gengiva, vagina e córnea. Outra grande participante desse mercado é a norte-americana MatTek, que vende vários modelos de pele equivalente, não muito distintos dos feitos pela L’Oréal. Os preços nas empresas, de amostras individuais, variam de US$ 50 a US$ 80. Na Alemanha, o Instituto Fraunhofer IGB criou um sistema automatizado capaz de produzir 12 mil fragmentos de pele a partir de uma única amostra de tecido humano. Desde 2014, o instituto alemão vende o sistema às empresas que querem certificar-se de que seus produtos de beleza não causam alergia ou irritação.
Embora a legislação brasileira permita a importação de pele artificial fabricada no exterior, isso nem sempre é viável – daí a importância do desenvolvimento do tecido no país. “Por ser material vivo e, portanto, perecível, os fragmentos de pele contidos nos kits têm validade de poucos dias. É muito comum enfrentarmos problemas na alfândega, o que na prática inviabiliza a importação”, diz a bióloga Silvya Stuchi Maria-Engler, professora da Faculdade de Ciências Farmacêuticas da Universidade de São Paulo (FCF-USP), referência nas pesquisas envolvendo pele equivalente. “Com a proibição do uso de animais em testes de cosméticos e insumos a partir de 2019, é muito importante que os kits passem a ser produzidos no país.”

No fim de 2015, o Grupo Boticário, controlador das unidades de negócio O Boticário, Eudora e Quem disse, Berenice?, anunciou ter conseguido criar um material equivalente à pele humana no seu Centro de Pesquisa e Desenvolvimento, em São José dos Pinhais, no Paraná. O tecido é empregado em testes de matérias-primas e produtos acabados, como maquiagens, loções e cremes, e em ensaios de segurança e toxicidade, no lugar de animais. “Para fazer nossa pele 3D, usamos células isoladas de tecidos cutâneos descartados de cirurgias plásticas, com o consentimento dos doadores e a aprovação do Comitê de Ética e Pesquisa de nosso Centro de P&D”, informa Márcio Lorencini, gerente de Pesquisa Biomolecular da companhia. Em laboratório, o novo tecido é formado célula a célula, camada por camada, tal como a pele humana. O resultado é um fragmento de até 3 centímetros de diâmetro pronto para realização de testes.
Na recriação in vitro, a epiderme, a camada mais externa da pele, é obtida por meio da cultura de queratinócitos, células que realizam a síntese da queratina e respondem pelos fatores de barreira e proteção, e dos melanócitos, responsáveis pela produção de melanina, que confere pigmentação à pele. A derme é reconstituída a partir da cultura de fibroblastos humanos cultivados em gel de colágeno. Os fibroblastos são responsáveis pela produção de proteínas capazes de sintetizar fibras de colágeno e elastina.
© LÉO RAMOS

Teste de cosmético líquido sobre pele artificial na USP. Cada fragmento só pode ser usado uma vez
Todas essas estruturas celulares produzidas em laboratório têm características de crescimento muito similares à pele humana, o que aumenta a uniformidade e a reprodutibilidade dos testes. E guardam muito mais semelhança com a pele humana do que a dos camundongos normalmente usados na avaliação de novos produtos. A pele completa formada por derme e epiderme é ideal para o estudo de doenças e a avaliação de novos medicamentos, enquanto a estrutura formada apenas pela epiderme é suficiente para ensaios de corrosão e irritação feitos pela indústria de cosméticos.
Pele 3D
A tecnologia do Grupo Boticário, segundo Márcio Lorencini, começou a ser desenvolvida em 2009. Com ela é possível realizar vários testes em uma mesma unidade de pele reconstituída. “A pele 3D permite maior amplitude e assertividade nos testes, por ser elaborada a partir de um conjunto de células de vários indivíduos [prática comum nas técnicas atuais de todos os grupos que pesquisam e produzem peles artificiais]. Utilizando um pool de células diminuímos a variabilidade individual. Caso empregássemos células derivadas de uma única pessoa poderíamos ter respostas variáveis de um indivíduo para outro, o que não é ideal para avaliação de parâmetros toxicológicos e de eficácia de produtos e matérias-primas cosméticas”, afirma Lorencini. Além dos ensaios de toxicidade, corrosão e irritação cutânea, a empresa usa a pele artificial para avaliação de eficácia da produção de melanina, análise de expressão gênica e proteica de diversos marcadores teciduais, como colágenos, elastinas e queratinas, e estudo de citocinas, que são biomarcadores de inflamação.
© LÉO RAMOS


A primeira amostra de pele humana reconstruída na USP foi finalizada em 2006
O Grupo Boticário desenvolveu o modelo com recursos próprios, sem o auxílio de parceiros na academia, mas contou em sua equipe com a participação da bióloga Carla Abdo Brohem, que fez sua formação no Laboratório de Biologia da Pele da USP, com bolsa de doutorado da FAPESP. Também com auxílio da Fundação, Carla realizou um pós-doutorado entre 2010 e 2011, ocasião em que estagiou no laboratório da pesquisadora australiana Pritinder Kaur, do Peter MacCallum Cancer Centre, instituição médica de Melbourne especializada na pesquisa e no tratamento de câncer. Pritinder é considerada uma grande especialista no estudo de células-tronco epiteliais e colabora com o grupo da professora Silvya Maria-Engler. Atualmente, Carla coordena o Núcleo de Avaliação de Segurança e Eficácia do Centro de P&D da companhia.
Em São Paulo, Silvya, coordenadora do Laboratório de Biologia da Pele da USP, finalizou seu primeiro modelo de pele humana reconstruída in vitro em 2006. Entre os trabalhos mais recentes, destacam-se o desenvolvimento de uma pele envelhecida para uso em testes de cosméticos antienvelhecimento, a criação de uma epiderme semelhante aos modelos comerciais e a produção de uma pele 3D voltada a estudos sobre câncer de pele. Essa linha de pesquisa já rendeu 45 artigos científicos publicados pelo grupo de Silvya.
“É fundamental que o Brasil domine a tecnologia de produção de pele humana reconstruída, ganhando autonomia nesse campo de pesquisa”, afirma a cientista. “Os modelos de pele completa e epiderme que criamos são idênticos aos produzidos no exterior. Estamos transferindo esse conhecimento para a sociedade por meio da Fundação Instituto de Pesquisas Farmacêuticas da USP, a FipFarma. Já fomos procurados por vários fabricantes de cosméticos interessados em receber treinamento para aprender a construir esses tecidos em laboratório”, diz ela.
A primeira empresa a fazer o curso de capacitação da USP foi a OneSkin Technologies, startup de biotecnologia especializada em engenharia de tecidos criada por três pesquisadoras brasileiras e sediada em São Francisco, na Califórnia. “Com o treinamento recebido na USP, conseguimos construir nosso modelo de epiderme humana in vitro. Agora, estamos trabalhando no desenvolvimento da pele completa”, conta a bioquímica Carolina Reis de Oliveira, sócia-fundadora da OneSkin. Incubada desde março deste ano na IndieBio, uma das maiores aceleradoras de biotecnologia dos Estados Unidos, a OneSkin quer dominar a tecnologia de construção de pele 3D para atuar no mercado de cosméticos antienvelhecimento. “Nosso próximo desafio é desenvolver um tipo de pele envelhecida que nos permita estudar mecanismos para prevenir o envelhecimento”, diz Carolina. Quando este objetivo for atingido, a OneSkin vai se dedicar à busca de moléculas com potencial antienvelhecimento. “Nossa ideia é licenciar moléculas relevantes ou produzir novos cosméticos com elas.” A OneSkin foi convidada a instalar-se na IndieBio após participar de um evento para startups no Brasil e chamar a atenção de investidores estrangeiros.
© ENRIQUE BOCCCARDO / USP
…e a pele artificial normal, em experimentos no Instituto de Ciências Biomédicas (ICB)
No Laboratório de Biologia da Pele da USP, a bióloga Paula Comune Pennacchi trabalha em uma linha de pesquisa similar à da OneSkin. Ela criou um modelo de pele humana que simula o envelhecimento cutâneo fisiológico e as alterações de pele observadas em pacientes diabéticos. O trabalho foi sua tese de doutorado, defendida em fevereiro deste ano. “Recriamos um modelo capaz de responder à ação de cosméticos e fármacos com ação sobre o envelhecimento cutâneo. Nossa pele reconstruída também contribuiu para o entendimento de fenômenos relacionados à deficiência de cicatrização e maior intensidade inflamatória em pele de pacientes diabéticos”, explica a pesquisadora.
Aguarda regulamentação
O Grupo Boticário não vai compartilhar a pele 3D construída em seus laboratórios enquanto não existir no Brasil a validação para esse tipo de produto. A francesa L’Oréal tomou a decisão de investir no Brasil nessa área e também aguarda a regulamentação para poder disponibilizar no país tecidos da linha Episkin, como já ocorre na Europa e na Ásia. “Enquanto não houver regulamentação clara para a distribuição dos tecidos, estamos no Brasil somente para fins de pesquisa. Por ano, produzimos na França aproximadamente 150 mil unidades de pele reconstruída, enquanto na China fabricamos outros 30 mil tecidos de pele pigmentada”, conta Rodrigo De Vecchi, gerente de Pesquisa Avançada da L’Oréal no Brasil. A princípio, a empresa implementa aqui apenas o modelo de epiderme humana reconstruída, conhecido pela sigla RHE, que usa em sua constituição queratinócitos humanos, o principal tipo celular epitelial. O RHE é um tecido aprovado pelo Comitê Europeu para Validação de Métodos Alternativos (Ecvam), para aplicação em testes de segurança em produtos cosméticos em substituição aos testes em animais. “Quando o modelo RHE estiver disponível no Brasil, contaremos com uma ferramenta para uso em cosméticos e também em áreas de pesquisa, como biomedicina, medicina regenerativa e avaliação toxicológica”, afirma De Vecchi.
© L’ORÉAL


Pele reconstruída da L’Oréal: pesquisas avançam para inserir neurônios no produto
Com a finalidade de refinar seu modelo de epiderme reconstruída, a L’Oréal fechou recentemente uma parceria com o Instituto D’Or de Pesquisa e Educação (IDor), do Rio de Janeiro. “Nossa proposta é reinervar o modelo de epiderme humana reconstruída com neurônios criados por nós, aproximando-a ainda mais da pele humana original”, conta o neurocientista Stevens Rehen, coordenador de pesquisas do IDor. Trata-se de uma pesquisa com enorme potencial biotecnológico, segundo o pesquisador, que também é professor do Instituto de Ciências Biomédicas da Universidade Federal do Rio de Janeiro (ICB-UFRJ). A área de interesse de Rehen é o estudo da biologia de células-tronco reprogramadas. “Desde 2014 firmamos a parceria com a L’Oréal voltada ao uso de células-tronco para a criação de modelos celulares humanos em laboratório”, diz. “Acreditamos que ao inervar a epiderme humana reconstruída com neurônios iremos aumentar a capacidade preditiva do modelo.”
Além de poder ser usada como plataforma para testes de cosméticos e produtos de higiene pessoal, a pele cultivada também é uma ferramenta para validação de novos medicamentos e estudo de doenças, entre elas papilomavírus humano (HPV) e melanoma. Na USP, estudos nessa linha são desenvolvidos no laboratório da professora Silvya e no Instituto de Ciências Biomédicas. Lá, o professor Enrique Boccardo desenvolveu um modelo de pele humana in vitro para investigar os mecanismos de transformação celular associados ao HPV e aprofundar pesquisas sobre o câncer de colo uterino causado pelo microrganismo. “Com apoio da FAPESP, eu trouxe essa tecnologia dos Estados Unidos em 2001, quando trabalhava no Instituto Ludwig de Pesquisas sobre o Câncer, em São Paulo”, conta Boccardo.
© GUILHERME PUPO


Produção de pele no Boticário: testes para toxicidade, corrosão e irritação cutânea
“Para estudar a fundo a biologia do vírus, introduzimos no Brasil um sistema de cultura de células in vitro que permite reproduzir o ambiente no qual o microrganismo cumpre seu ciclo. Esse tecido, semelhante à pele, é composto por queratinócitos humanos, colágeno e fibroblastos”, explica Boccardo. “Temos utilizado o modelo para analisar os mecanismos moleculares empregados pelo vírus para escapar da resposta imune do organismo e entender como o HPV manipula a célula a fim de sintetizar seu material genético e reproduzir novas partículas virais.”
Na Faculdade de Ciências Farmacêuticas da USP, a pesquisadora pós-doutoranda Fernanda Faião Flores recorre ao tecido artificial desenvolvido pelo grupo da professora Silvya Maria-Engler para estudar os mecanismos de resistência ao melanoma, a forma mais letal de câncer de pele. “Utilizamos linhagens celulares, amostras de pacientes e um modelo de pele humana reconstituída in vitro que mimetize a invasão e a disseminação das células de melanoma”, conta. “Com isso, testamos compostos e conseguimos caracterizar o fenômeno de resistência a um medicamento, chamado vemurafenibe, que inibe a atividade proliferativa do tumor.” A pele reconstruída com melanoma serviu para avaliar o composto como possível agente quimioterápico.
Tratamento de queimados
Na área médica, outra opção é o emprego de pele humana reconstituída e terapia celular com transplante de células cutâneas para o tratamento de úlceras de pele e queimaduras em pacientes. Em Campinas, a dermatologista Maria Beatriz Puzzi, coordenadora do Laboratório de Cultura de Células de Pele da Faculdade de Ciências Médicas da Universidade Estadual de Campinas (FCM-Unicamp), estuda a recriação do tecido celular em laboratório para enxerto feito a partir de células isoladas do próprio paciente, o que faz com que ambos os tecidos – a pele natural e a reconstituída – tenham estrutura muito semelhante, possibilitando a realização de transplantes autólogos (em que se utiliza tecido de um mesmo indivíduo) com menor risco de rejeição. “O problema dessa metodologia é que a recriação de pele em laboratório leva em torno de 45 a 60 dias – e os pacientes queimados precisam do tratamento imediatamente”, explica Maria Beatriz.
Para contornar esse problema, no lugar do implante da pele reconstruída, o grupo decidiu empregar a terapia celular com células da pele. “Tiramos um pedacinho da pele do paciente, isolamos os queratinócitos e os fibroblastos e fazemos o cultivo dessas células em laboratório. Em 15 dias, elas são misturadas a um gel e aplicadas no paciente. Em pouco tempo, espalham-se nas lesões reconstruindo a pele”, conta. “Temos resultados muito positivos com essa rota, que acelera a cicatrização, encurta o tempo de hospitalização e reduz a morbidade dos pacientes.”
Métodos alternativos à experimentação animalUso de tecidos reconstruídos no Brasil depende de um custoso processo de validação
O Brasil é o quarto maior mercado global de produtos de beleza, superado por Estados Unidos, China e Japão. As cerca de 2,5 mil empresas do segmento faturaram R$ 42,6 bilhões em 2015, de acordo com a Associação Brasileira da Indústria de Higiene Pessoal, Perfumaria e Cosméticos (Abihpec). A partir de 2019, qualquer novo produto de beleza deverá obrigatoriamente passar por testes dermatológicos em peles humanas reconstruídas, no Brasil ou no exterior. “Não existem estudos que apontem o tamanho do mercado de pele equivalente no Brasil, mas teoricamente ele deve ser expressivo, já que muitos lançamentos de cosméticos ocorrem todos os anos”, afirma a professora Silvya Maria-Engler, da USP, que integra o Conselho Científico da Abihpec.
A obrigatoriedade de substituição de testes em animais por modelos de pele equivalente foi determinada há dois anos pelo Conselho Nacional de Controle de Experimentação Animal (Concea), órgão integrante do Ministério da Ciência, Tecnologia, Inovações e Comunicações (MCTIC), responsável por estabelecer normas para experimentação animal no Brasil. A entidade reconheceu 17 métodos alternativos ao uso de animais em atividades de pesquisa, dos quais dois preveem o uso de epiderme humana equivalente para validação de cosméticos. “Um destina-se à verificação do potencial de irritação dos novos produtos e o outro serve para avaliação da corrosão das substâncias testadas”, destaca o ex-coordenador do Concea, José Mauro Granjeiro. Esses dois métodos alternativos foram referendados pela Organização para a Cooperação e Desenvolvimento Econômico (OECD), entidade que aprovou os métodos empregados na Europa e que serviram de base para elaboração da norma brasileira.
“A pele 3D que desenvolvemos na USP foi criada para estudos científicos, mas pode ser usada comercialmente, desde que passe por um processo de validação”, conta Silvya. Nesse processo, amostras da pele cultivada in vitro devem ser submetidas a uma extensa bateria de testes, a um custo aproximado de R$ 1 milhão. Em geral, de um a três laboratórios independentes participam da validação, que é coordenada pelo Centro Brasileiro para Validação de Métodos Alternativos (Bracvam) com apoio da Rede Nacional de Métodos Alternativos (Renama), criada em 2012 pelo governo federal. “Por causa do alto custo, ele só é viável com apoio de empresas e laboratórios privados”, ressalta a farmacêutica-bioquímica Silvia Berlanga Barros, professora da FCF-USP. Ela participou da criação da pele artificial no grupo de Silvya Engler.
Projetos
1. Desenvolvimento de pele artificial contendo equivalente dérmico glicado na avaliação da eficácia e toxicidade de compostos antiglicação (nº 2011/14327-6); ModalidadeAuxílio à Pesquisa – Regular; Pesquisadora responsável Silvya Stuchi Maria-Engler (USP); Investimento R$ 85.925,35.
2. Geração de peles artificiais humanas e melanomas invasivos como plataforma para testes farmacológicos (nº 2008/58817-4); Modalidade Auxílio à Pesquisa – Regular; Pesquisadora responsável Silvya Stuchi Maria-Engler (USP); Investimento R$ 165.075,55.
3. Impacto da expressão de reck no controle da invasão de melanoma: Estudo em monocamadas e pele artificial (nº 2010/50157-5); Modalidade Bolsa no País – Pós-doutorado; Pesquisadora responsável Silvya Stuchi Maria-Engler (USP);Bolsista Carla Abdo Brohem (USP); Investimento R$ 32.690,51.
4. Estudo da possível implicação de p53 nos efeitos do fator de necrose tumoral-alfa (TNF-alfa) sobre células imortalizadas por papilomavírus humano (HPV) (nº 1998/07087-2); Modalidade Bolsa no País – Regular; Pesquisadora responsávelLuisa Lina Villa/USP; Bolsista Enrique Mario Boccardo Pierulivo (USP);Investimento R$ 104.861,71.
5. Análise da expressão de proteínas de polaridade em processos neoplásicos associados ao papilomavírus humano utilizando culturas organotípicas. (FAPESP-Conicet) (nº 2012/51017-8); Modalidade Auxílio à Pesquisa – Regular; Pesquisador responsável Enrique Mario Boccardo Pierulivo (USP);Investimento R$ 22.988,33.
Fonte: Revista Pesquisa Fapesp


Comentários